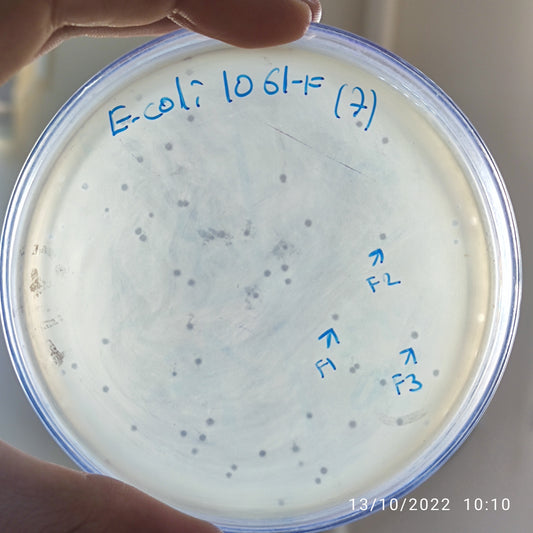
Escherichia coli bacteriophage 101061F
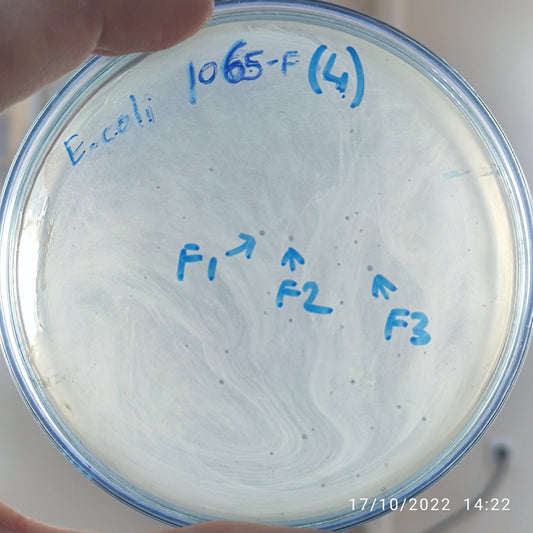
Escherichia coli bacteriophage 101065F
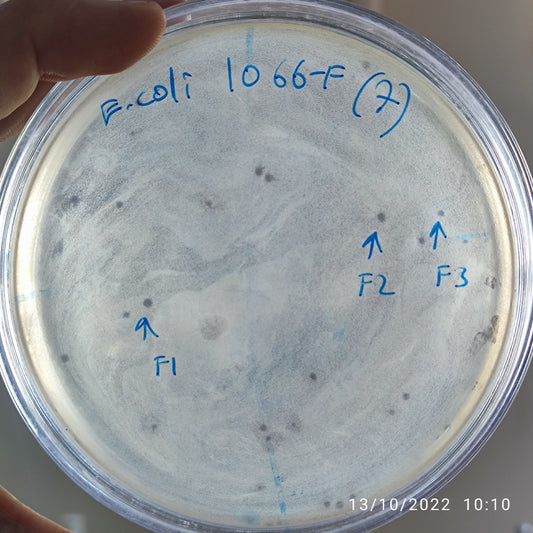
Escherichia coli bacteriophage 101066F
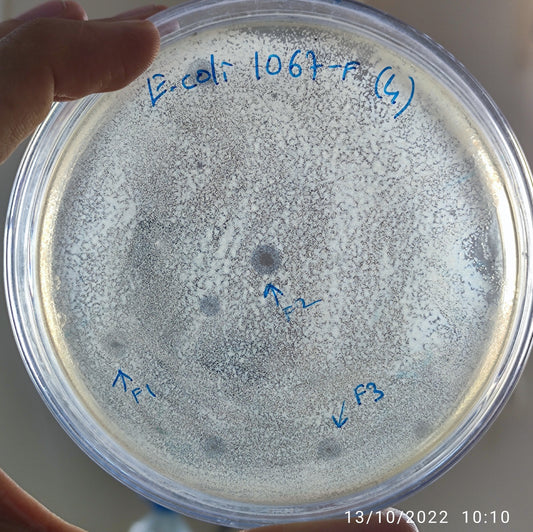
Escherichia coli bacteriophage 101067F
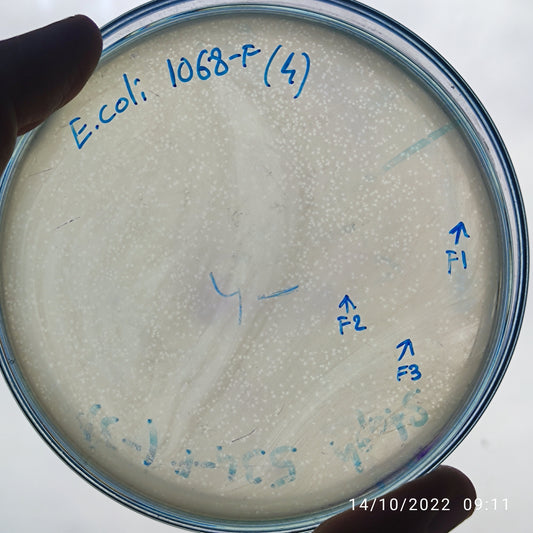
Escherichia coli bacteriophage 101068F
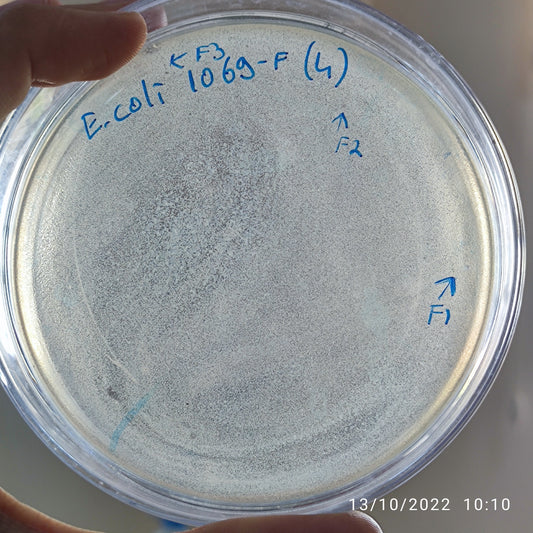
Escherichia coli bacteriophage 101069F
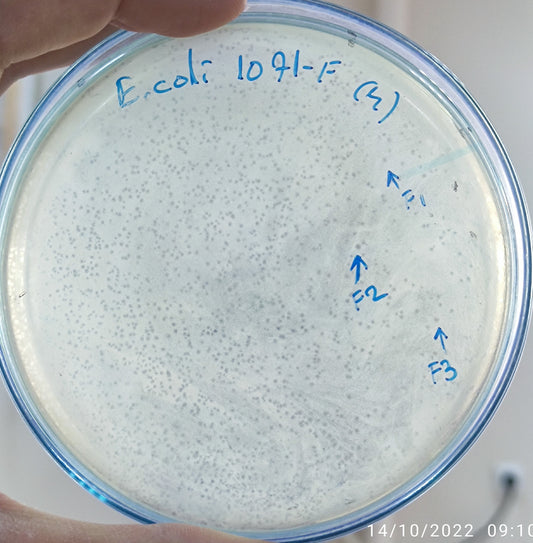
Escherichia coli bacteriophage 101071F
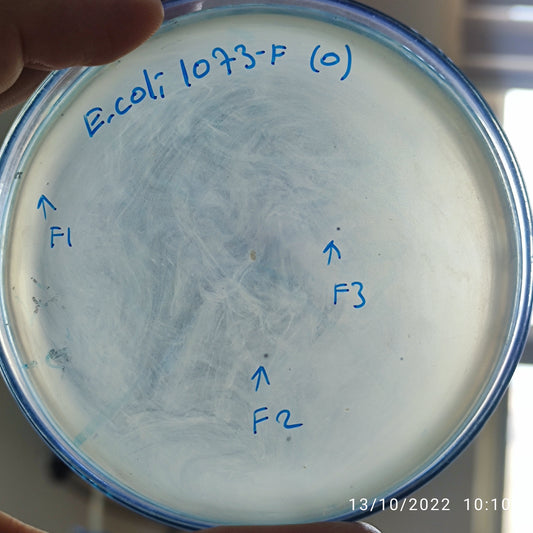
Escherichia coli bacteriophage 101073F
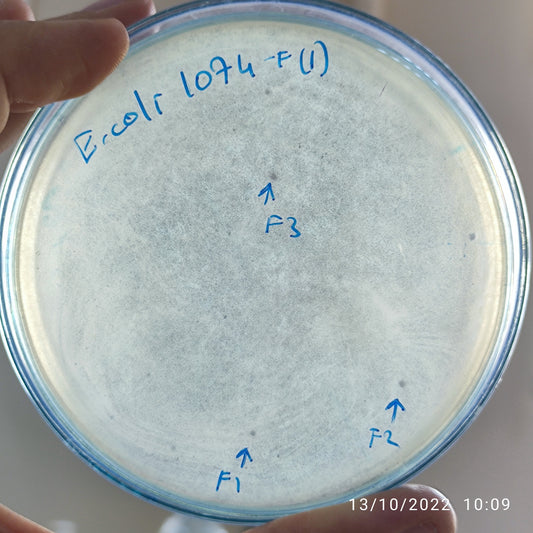
Escherichia coli bacteriophage 101074F
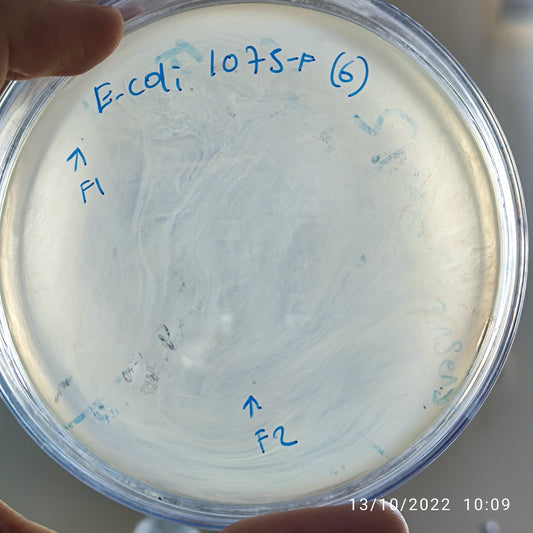
Escherichia coli bacteriophage 101075F
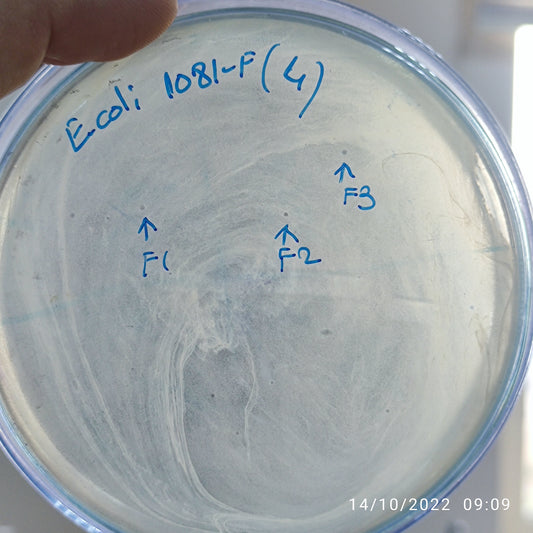
Escherichia coli bacteriophage 101081F

-
Escherichia coli bacteriophage 101060F
Regular price $850.00 USDRegular priceUnit price per -
Escherichia coli bacteriophage 101061F
Regular price $800.00 USDRegular priceUnit price per -
Escherichia coli bacteriophage 101065F
Regular price $500.00 USDRegular priceUnit price per -
Escherichia coli bacteriophage 101066F
Regular price $500.00 USDRegular priceUnit price per -
Escherichia coli bacteriophage 101067F
Regular price $750.00 USDRegular priceUnit price per -
Escherichia coli bacteriophage 101068F
Regular price $500.00 USDRegular priceUnit price per -
Escherichia coli bacteriophage 101069F
Regular price $500.00 USDRegular priceUnit price per -
Escherichia coli bacteriophage 101070F
Regular price $500.00 USDRegular priceUnit price per -
Escherichia coli bacteriophage 101071F
Regular price $500.00 USDRegular priceUnit price per -
Escherichia coli bacteriophage 101073F
Regular price $700.00 USDRegular priceUnit price per -
Escherichia coli bacteriophage 101074F
Regular price $600.00 USDRegular priceUnit price per -
Escherichia coli bacteriophage 101075F
Regular price $500.00 USDRegular priceUnit price per -
Escherichia coli bacteriophage 101076F
Regular price $500.00 USDRegular priceUnit price per -
Escherichia coli bacteriophage 101077F
Regular price $600.00 USDRegular priceUnit price per -
Escherichia coli bacteriophage 101081F
Regular price $500.00 USDRegular priceUnit price per -
Escherichia coli bacteriophage 101084F
Regular price $500.00 USDRegular priceUnit price per